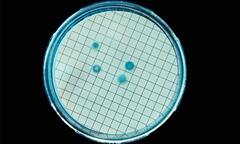
Vi khuẩn bám đầy điện thoại- người dùng coi chừng

Vi khuẩn bám đầy điện thoại- người dùng coi chừng
(ĐSPL)-Không được rửa, chỉ được lau chùi và được mang đi khắp nơi chính là lý do khiến những chiếc điện thoại trở thành ngôi nhà lý tưởng cho hàng loạt loại vi khuẩn.
(ĐSPL)-Không được rửa, chỉ được lau chùi và được mang đi khắp nơi chính là lý do khiến những chiếc điện thoại trở thành ngôi nhà lý tưởng cho hàng loạt loại vi khuẩn.

(ĐSPL)- Sạc bằng sóng radio là một phát mình mới đầy hứa hẹn. Nó có thể gửi tín hiệu điện sạc ở khoảng cách 3,5m khiến cho người sử dụng nhiều tiện lợi.

(ĐSPL)- Theo Quyết định số 16/2015/QĐ-TTg ngày 22/5/2015 của Thủ tướng Chính phủ, từ 1/7/2016 sẽ thu hồi và xử lý một số sản phẩm thải từ rác điện tử.

(ĐSPL)- Nghe điện thoại lúc đang ngồi câu cá, người đàn ông ở thành phố Hồ Chí Minh không thể ngờ được tai họa lại sắp sửa sập xuống với mình.

(ĐSPL) Website của Samsung Mỹ vừa bất ngờ đăng tải thông tin về chiếc Galaxy S6 Active lên website của mình.

Cục thương mại điện tử - Bộ Công thương đang yêu cầu Công ty Bkav Security hoàn thiện thủ tục đăng ký kinh doanh thương mại điện tử với website bkav.com.vn.

(ĐSPL)- Mẫu máy ảnh Sony Alpha A7R bất ngờ được giảm giá một cách không tưởng trên gian hàng online của Sony tại khu vực Mỹ khiến nhiều người háo hức.

(ĐSPL)- Sự ra đời của hệ thống định vị cung cấp thêm các lựa chọn dịch vụ định vị cho người sử dụng trên toàn cầu.

(ĐSPL)- Mới 2 ngày tung ra thị trường, BKAV cho biết đã có gần 5000 chiếc được bán ra.

(ĐSPL)- Trang bị khả năng chống nước trên smartphone đang là một xu hướng hiện nay, và thực tế đây là một tính năng thiết thực cho người dùng.

(ĐSPL) - Chiếc điện thoại “đẹp nhất nhì thế giới” Bphone vừa ra mắt cách đây ít ngày hiện đã được hãng Bkav xúc tiến nhanh cho người dùng đặt mua trước qua mạng.

(ĐSPL)- Điện thoại giá rẻ, chất lượng cộng thêm màn hình full HD luôn là tầm ngắm lý tưởng cho người tiêu dùng lựa chọn.

(ĐSPL) - Các nhà khoa học đã cam kết chỉ trong vòng 10 năm nữa máy tính có thể giống con người, kể cả tán tỉnh phụ nữ.

Mẫu máy ảnh Sony Alpha A7R bất ngờ được giảm giá một cách không tưởng trên gian hàng online của Sony tại khu vực Mỹ

(ĐSPL)- Hai nhà thiết kế người Pháp vừa cho ra mắt một chiếc bàn bằng gỗ sồi có cấu tạo đặc biệt, hoạt động như một chiếc điều hòa nhiệt độ nhưng lại không sử dụng điện n

(ĐSPL - Điện thoại di động giúp mọi người giao tiếp với nhau một cách hiệu quả và dễ dàng, nhưng sử dụng nó quá mức có thể gây ảnh hưởng lớn đến sức khỏe của bạn.

(ĐSPL)- Một chiếc laptop màn hình cảm ứng sẽ đem lại nhiều tiện ích cho bạn khi làm việc. Tuy nhiên nó cũng còn nhiều điểm hạn chế cần phải cân nhắc.

(ĐSPL)- Pin điện thoại của bạn nhanh hết, nhanh hỏng vậy làm thế nào để làm nó bền hơn. Dưới đây là một vài gợi ý giúp pin điện thoại của bạn trường thọ

Nhạc chuông điện thoại Bphone của BKAV ngay sau khi được giới thiệu "bản độc quyền" đã gây bão trên mạng xã hội, nhiều ý kiến cho rằng BKAV đã đạo nhạc..

(ĐSPL)- Smartphone giá rẻ trong tâm lí của nhiều người đều mặc định đó là hàng chất lượng không tốt. Suy nghĩ đó hoàn toàn sai lầm.

(ĐSPL)- Mạo hiểm để có một bức hình độc - đẹp, không ít người đã phải mất cả tính mạng.
.jpg)
(ĐSPL) - Bphone của Bkav sẽ sử dụng màn hình cảm ứng 5 inch, vỏ nhôm nguyên khối với thiết kế bo tròn các góc...

(ĐSPL) - Bphone sẽ chính thức ra mắt thị trường Việt hôm nay (26/5) sau một chuỗi thời gian chờ đợi khá dài của cộng đồng công nghệ.

(ĐSPL) - Bphone- "điện thoại đẹp hơn iPhone' sẽ chính thức ra mắt vào hôm nay 26/5. Được biết, chi phí cho lễ ra mắt này của tập đoàn Bkav lên tới hơn 10 tỷ đồng...

(ĐSPL)- Bạn hay đi công tác nên thời gian di chuyển trên đường nhiều, cần có một chiếc Laptop có thời lượng pin khủng. Dưới đây là 5 mẫu laptop có pin tốt nhất hiện nay.

(ĐSPL)-Sạc điện thoại nếu không cẩn thận sẽ gây chập và cháy nổ gây ảnh hưởng đến tính mạng cũng như tài sản xung quanh bạn. Dưới đây là một vài gợi ý sạc pin an toàn.

(ĐSPL)-Trong vài năm gần đây, an ninh mạng luôn là một vấn đề nóng bỏng và người dùng thường xuyên phải đối mặt với nguy cơ bị tin tặc tấn công bất kỳ lúc nào.

Cuối tháng luôn là thời điểm nhiều hãng điện thoại đua nhau giảm giá nhằm tăng doanh thu về cho mình. Đây là cơ hội cho người tiêu dùng sở hữu smartphon ưu đãi.

(ĐSPL)- Những bí mật nhỏ ẩn chứa sau logo của Apple, nét ma mị đến từ thương hiệu Canon, tất cả đã tạo nên một phần bản sắc của các tập đoàn công nghệ hàng đầu thế giới

(ĐSPL)- Nếu bạn đang có những thói quen dưới đây với chiếc laptop của mình, hãy dừng lại và thay đổi để bảo vệ máy tính của bạn một cách tốt nhất nhé.